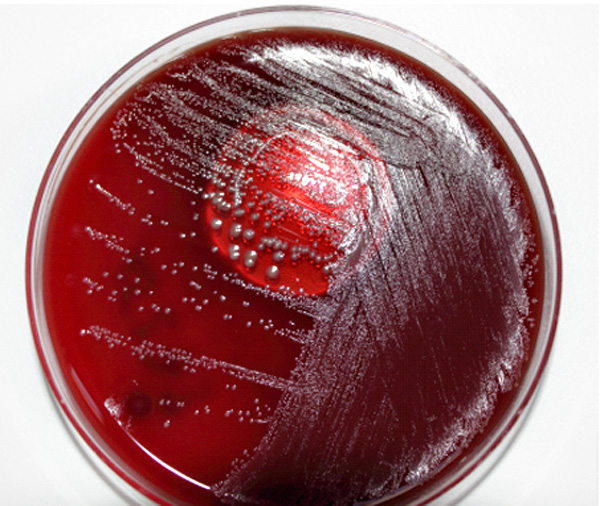

Un medio de cultivo es una técnica de laboratorio que consta de una solución con los nutrientes necesarios para permitir,. Agar sangre Columbia. Es un medio utilizado en la microbiología clínica para el aislamiento de bacterias gram positivas (estafilococos o estreptococos) desde diferentes muestras, pues es una base para el crecimiento.. Mueller Hinton Sangre Agar . Medio de cultivo recomendado universalmente para la realización de la prueba de sensibilidad a los antimicrobianos en las cepas de Streptococcus pneumoniae, Streptococcus grupo viridans y Streptococcus grupo Beta Hemolítico. Papa Glucosado Agar . Medio de cultivo adecuado para el aislamiento y recuento de hongos y.

Placa Agar Sangre con bacterias Carlos Rosas Flickr

AGAR MUELLER HINTON Medio de cultivo Agar Mueller Hinton Lab Medibac

Cómo preparar medios de cultivo Agar Gelosa Sangre YouTube

Cultivo de agar sangre. medicne microbiology Petri dishes, Food, Dishes

El agar MacConkey es un medio de cultivo selectivo y diferencial para bacterias. Está diseñado

Medio de Cultivo Agar Sangre Quinsa

Videotutorial para la preparación de Agar Sangre YouTube

Cultivo de colonias bacterianas en agar sangre en microbiología Foto Premium

Como preparar medios de cultivo, agar sangre, agar sal y manito y agar EMB YouTube

1. Cultivo en el medio Agar sangre (Staphylococcus aureus). Download Scientific Diagram

Medio de agar sangre en placa petri, laboratorio de microbiología. pruebas de cultivos

agar medio de cultivo de laboratorio clínico microbiología Stock Photo Alamy

Medio de agar sangre en placa petri, laboratorio de microbiología. pruebas de cultivos

Cultivo de especies de Bacillus en Agar Sangre. a). B. licheniformis,... Download Scientific

Medios de cultivo Agar Sangre presentacion PDF

Preparación medio de cultivo Agar Sangre y Agar Macconkey YouTube

PRÁCTICA 15 COPROCULTIVO
La biología mola AGARAGAR

Cultivo en Agar Sangre Laboratorio, Agar

Agar MacconKey Medio de cultivo sólido Selectivo y
Ejemplo: Agar Sangre. Naturales. Son medios preparados a partir de sustancias naturales. Ejemplo: agar papa, agar zanahoria. Según su finalidad. Selectivos.. Los medios de cultivo sólidos poseen agar como agente solidificante. Su disolución completa se realiza a baño de María y se visualiza cuando al agitar el medio no se adhiere.. El agar manitol sal, también conocido como manitol salado, es un medio de cultivo sólido que sigue siendo utilizado para el aislamiento de "Staphylococcus aureus", aunque en este caso el poder inhibitorio sobre el resto de bacterias es más fuerte. Es decir, es más selectivo que el anterior. 1.11. Agar BCYE.